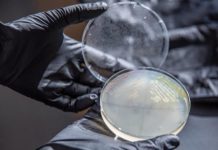
Research: Engineered microbe may be key to producing plastic from plants —

Research: Scientists engineer mouse ‘smart house’ to study behavior —
Researchers at the Francis Crick Institute have developed a 'smart house' for mice, that allows them to study the animals' behaviour with minimal...
Research: Scientists find differentiating cells do not all respond the same when told to...
Rice University scientists have found significant differences between the methods signaling pathways use to prompt cells to differentiate -- that is, whether to...
Research: Star Wars and Asterix characters amongst 103 beetles new to science from Sulawesi,...
The Indonesian island of Sulawesi has been long known for its enigmatic fauna, including the deer-pig (babirusa) and the midget buffalo. However, small...
Research: Mechanical engineers create synthetic, sound-silencing structure that blocks 94 percent of sounds —
Boston University researchers, Xin Zhang, a professor at the College of Engineering, and Reza Ghaffarivardavagh, a Ph.D. student in the Department of Mechanical...
Research: Vast record of past climate fluctuations now available thanks to laser imaging of...
Shellfish played a significant role in the diet of prehistoric coastal populations, providing valuable nutrients. They are a common find in archaeological sites...
Research: Changing weather is triggering melting —
Rainy weather is becoming increasingly common over parts of the Greenland ice sheet, triggering sudden melting events that are eating at the ice...
Research: Engineered microbe may be key to producing plastic from plants —
With a few genetic tweaks, a type of soil bacteria with an appetite for hydrocarbons shows promise as a biological factory for converting...
Research: Study upends ideas inferred from nonwoody plants —
North Carolina State University researchers have uncovered how a complex network of transcription factors switch wood formation genes on and off. Understanding this...
Research: Culturally sensitive conservation approaches needed to protect Ethiopian church forests —
Human disturbance reduces forest density, biomass, and richness of species in sacred church forests of northern Ethiopia, according to new research by Catherine...
Research: Rethinking old-growth forests using lichens as an indicator of conservation value —
Two Canadian biologists are proposing a better way to assess the conservation value of old-growth forests in North America -- using lichens, sensitive...
Top News
Hey ISIS, You Suck: Local Muslims Post Anti-ISIS Billboard
A new billboard on Manchester Road in Missouri reads, "HEY ISIS, YOU SUCK!!! From: #ActualMuslims."
A group of Muslim-Americans have put up a blunt billboard...